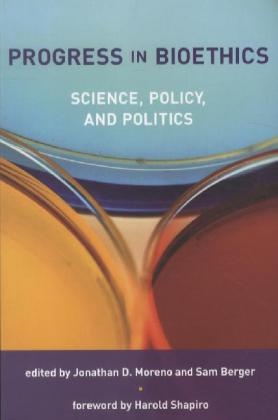
Jonathan D Moreno, Jonathan D. Moreno, Jonathan D. (EDT)/ Berger Moreno, Jonathan D. Berger Moreno, Sam Berger, … - Progress in Bioethics Science, Policy, and Politics

Jonathan D. Moreno in Bücher - Alle
Artikel von Jonathan D. Moreno anzeigen im kompletten Shop
Everybody Wants to Go to Heaven but Nobody Wants to Die
Englisch
27.09.2019
Fester Einband
CHF 39.50
Global Bioethics: The Impact of the UNESCO International Bioethics Committee
Englisch
01.11.2015
Fester Einband
CHF 70.00
Global Bioethics: The Impact of the UNESCO International Bioethics Committee
Englisch
01.01.2016
Taschenbuch
CHF 70.00
The Qualitative-Quantitative Distinction in the Social Sciences
Englisch
18.10.2010
Taschenbuch
CHF 135.00
The Qualitative-Quantitative Distinction in the Social Sciences
Englisch
29.06.2009
Fester Einband
CHF 134.00
In the Wake of Terror: Medicine and Morality in a Time of Crisis
Englisch
01.02.2003
Fester Einband
CHF 17.40